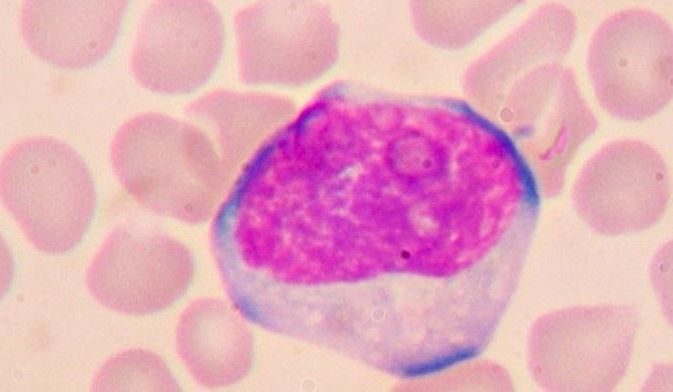

Dieta ketogeniczna - na czym polega, zasady, wady i zalety
13.02.2024
9 minut

13.02.2020
4 minuty
Przez telefon można zarezerwować wakacje, bilet lotniczy czy miejsce w hotelu. Wszystko. Tylko ten mały ekran, w który nieustannie się wpatrujemy może stać się również przyczyną naszych różnorodnych dolegliwości.

4.02.2020
4 minuty
W dobie panującego trendu na piękne i zdrowe ciało jesteśmy gotowi wypróbować każdą metodę, która może przynieść pożądane efekty.

13.01.2020
3 minuty
Masaż relaksacyjny to idealna forma relaksu dla ciała oraz duszy. Masaż świetnie nadaje się do rozluźnienia mięśni po ciężkim dniu pracy czy treningu.

25.03.2019
5 minut
Przesilenie wiosenne najczęściej rozpoznawane jest po objawach, takich jak senność, brak nastroju czy koncentracją. Zachęcamy do przeczytania.

5.11.2018
4 minuty
Mimo stosowania różnorodnych diet, wysokiej aktywności fizycznej, kilogramy nie chcą ubywać. Co wtedy zrobić? Gdzie szukać pomocy?

29.10.2018
12 minut
Grypa jest chorobą, która dotyka wielu osób każdego roku. Jesienią organizm musi zmierzyć się z nie lada wyzwaniami, jakie stawia przed nim pogoda.
6.08.2018
7 minut
Limfocyty, to nasza osobista broń chroniąca przed wirusami, bakteriami i innymi czynnikami chorobotwórczymi. Bez nich pokonałaby nas najzwyklejsza infekcja.
13.02.2024
9 minut
22.10.2021
11 minut
15.02.2024
10 minut
20.02.2020
8 minut
23.07.2024
8 minut
Lekarze w popularnych lokalizacjach - znajdź lekarzy w Twojej okolicy.